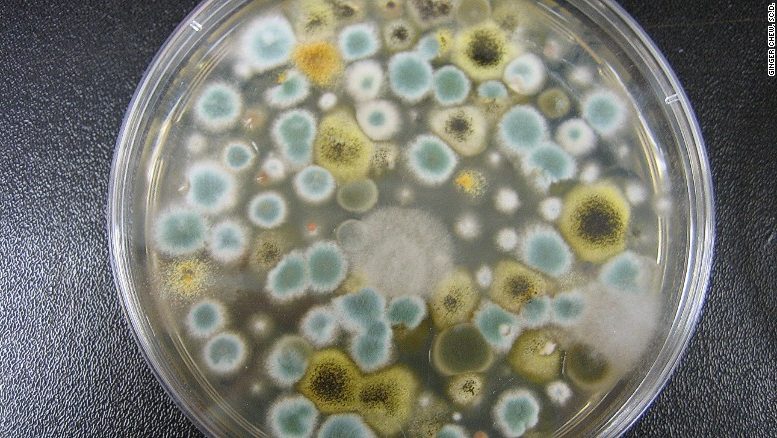

Minor service leak can sometime results in serious problems in particular if they are ignored or not fixed properly. I have recently visited an apartment where a minor water leak from a bath waste pipe resulted in a major mould contamination of the internal cavity walls. The apartment I have visited was located on the 5th floor of an inner city apartment complex. The flat consisted of two bedrooms, living room, kitchen, bathroom and a store room. The partition walls were mainly plasterboard with insulation infill and ceilings in the whole property are plasterboard.
The property occupied only for a short time when the owners noticed that something is not right. They have noticed strong odours in the bathroom and the kitchen which could be described as damp and fungus related. Fortunately at the time of my inspection the occupants did not currently suffer from any adverse health symptoms. Prior to them moving into the property there was a long term water leak in the bathroom area which has caused a significant deterioration of the bathroom floor. The water leak was identified and repaired prior the commencement of the occupancy.

I have carried out a moisture survey of the property and identified a minor water leak under the bathroom which caused significant deterioration and fungal rot to the underlying timber floor. I have noticed the presence of live and active macroscopic wood rotting fungi directly under the areas of the leak.

I have also investigated the moisture content of the partition wall between the bathroom and kitchen which appeared to be normal. Unfortunately also in this area I have noticed a significant mould growth on the external and internal sided of the plasterboard panelling. The total extent of the mould contamination was between 10-15m2. Inspection of the kitchen areas identified a significant extent of mould contamination to plasterboard wall panelling behind kitchen units and inside of the kitchen cavity wall. The relative moisture content of the wall plasterboard is normal indicating historic contamination currently in dormant state. This area is directly connected to with the bathroom areas via opening in the plasterboard partition wall. This area is also a significant source of damp and mould related odours in the property.

I have collected a number of air samples from the property to evaluate the level of indoor air contamination by mould spores. My assessment showed there was marginally lower concentration of mould spores in the indoor environment in comparison to the external background sample. The indoor air samples were however dominated by Aspergillus/Penicillium genera and also mould genera such as Stachybotrys and Chaetomium frequently associated with water damage were also identified indoors in relatively small concentrations.

The surface samples collected from the visible mould contamination on various surfaces within the property show presence of mainly water damage moulds such as Stachybotrys and Chaetomium.


In my assessment I have concluded that the most likely reason for odours in the property is continuous fungal rot of the bathroom timber flooring and large extent of fungus contaminated plasterboard panelling in both the bathroom and the kitchen. The indoor air is not significantly contaminated by fungal spores, however water damage (Chaetomium) and toxic (Stachybotrys) fungal genera have been detected indoors. I have strongly recommended to remove the water damaged and rotten timber flooring and remove existing fungal contamination to the walls of the kitchen and bathroom. The removal of the contaminated materials should be carried out under controlled conditions.
By Tomas Gabor
Mould vs Your Health
Mould is associated with damp buildings and can trigger nasal congestions, coughing, sneezing, wheezing, and respiratory infections and worsen asthma and allergic conditions. People who are most susceptible to these types of symptoms and other serious health effects include those with:
- Weakened immune systems
- Asthmatics
- Chronic, obstructive, or allergic lung diseases
- Allergies

If you are concerned about having mould you should seek medical advice and professional health to review, damp and mould. For more information, go to Sysco-env.com.
Mould will only grow when the environment is habitable with sufficient moisture on a surface or humidity in the air. The most common causes are:
- Damaged downpipes and gutters with leaky roofs and walls allowing moisture in
- Damaged plumbing
- Condensation from daily activities such as cooking, showering.
- Poor ventilated areas with poor circulation, eg cupboards, corners, and furniture against uninsulated outside walls.
The best thing you can do is prevent mould by elimitating excess moisture. You can do this by
- Fixing leaky plumbing and damaged roofs/walls
- Ensure gutters are maintained
- Reduce condensation (increase ventilation when carrying out activities such as cooking/showering)
- Wipe up excess water caused by condensation
- Air the home regularly
- Use dehumidifiers
- Maintain heating, ventilation, and cooling systems
- Vacuum
- Increase air cirulation around furniteure by moving the futniture away from walls.
When mould is visible, it’s not considered necessary to test for it in the home. However, not all mould is visible and you may experience symptoms without knowing you have mould contamination in the cavities of your ceiling etc. If you can see or smell mould, you need to clean up and remove the mould immediately, as the mould can damage surfaces it grows on. If you are unsure if you have a mould and would like to do a home test to find out, you can purchase a mould test kit from our website, if you want a more in-depth report regarding mould contamination you can purchase the mould test kit plus.
If you know, or suspect you have a mould but are unsure of the source, Sysco environmental can assist you by sending out a train professional occupational hygienist to come and inspect your home to find the source.
Do not hesitate to get in touch for more information and a free quote regarding a home inspection. Contact us here
Types of Mould Contamination
Whilst you may see mould as just a fuzzy gunk growing in your basement, there are actually different types of mould, some of which can pose a serious threat to your health especially when in your home. Here are a few common species of toxic mould that may be what is contaminating your home wherever there are damp surfaces or water damage.
Aspergillus
This specific type of mould is something that you most likely breathe in every single day, although the spores are common, this type of mould can be particularly dangerous to those with a compromised immune system. Exposure to this species can cause allergic reactions, lung infections, and an infection known as aspergillosis.
Penicillium
Similar to Aspergillus, this type of mould is common in most everyday environments. However, when infested inside your home it can cause asthmatic symptoms, bronchitis and many other respirtory issues. If these symptoms begin to appear, don’t wait for it to just go away, contact a professional or purchase a test kit to find out what you’re dealing with.

Stachybotrys
You may know this species better by its common name “black mould”, it is one of the most dangerous species of mould and can cause flu-like symptoms which are easily looked over such as:
- Diarrhea
- Headaches
- Memory loss
- Severe respiratory damage
Children are the most at risk with health problems caused by black mould due to their lungs still developing. Just like its nickname “black mould”, this type of species is dark in colour, often black, grey, or dark green and typically has a very musty odour. You will find this mould growing in very damp areas, most likly with a leak.

Chaetomium
This is commonly found in homes that are experiencing water damage and it loves dark, wet environments and will thrive on drywall, wallpaper, baseboards, and even carpets. This is very similar to Stachybotrys and often will share the same environment. The health effects you may experience when exposed to this species are
- Red/watery eyes
- Trouble breathing
- Neurological damage
- Autoimmune diseases

If you experience any of the symptoms above from any of the types of mould, or suspect mould in any way, do not hesitate to contact a professional to get it checked out, you could be at risk from mould exposure which leads to serious health effects.
Preventing Mould in your Home
The best way to prevent mould contamination in your home is to control the level of moisture. Although it is impossible to remove all spores in an indoor environment, the mould spores will not grow in the absence of moisture, controlling moisture is the key to preventing mould infestations.
- It is vital to identify and repair any problems that could lead to excess moisture, such as leaks in plumbing or other structural problems that could cause leaks, such as your roof.
- Clean and cry areas that may have been effected by a leak.
- You can use a dehumidifier or air conditioner during humid weather to help reduce the potential for moisture build up.
- Avoid the use of carpets in cellars and bathrooms.
- Using fans and maintaining good ventilation throughout the house can improve IAQ (Indoor Air Quality) and help prevent dampness.
- Keep indoor humidity levels low.
- Vent appliances that can produce moisture, such as dryers.
- Insulation can also reduce the potential for condensation on cold surfaces, such as windows and outer walls.
Sysco Environmental can help with any biological contaminant needs and also offer a DIY mould test kit which allows you to identify if you have any exposure in your home. Do not hesitate to get in touch for more information and a free quote regarding a home inspection. Contact us here
Testing your Home for Mould
Sysco Environmental can assist with mould contamination, but first you need to identify if there is mould in your building. You can request for a hygienist to come out and give a full survey of your home, which will allow you to benefit from
- Survey, sampling and analysis carried out to ISO (International standards)
- Sampling in every room for bacteria and mould
- Accurate root cause identification
- Damp survey of the property
- Thermographic survey of the property
- Employees, visitors, and occupants health risk evaluation (For businesses)
- Accurate, reliable defendable data
This service will provide very reliable data of the IAQ in the building and the concentration of contamination. The report you will recieve at the end of the survey will state whether the property is deemed habitable or not as well as the type of mould you’re dealing with and the level of concenration.

However, you can also access the building yourself through a Mould Testing Kit. This DIY kit is designed to easily allow you to test for mould contamination, and whether you have more spores indoors than out, the Mould Test Kit Plus will allow you to test multiple rooms and also get a report explaining which room has the highest concentration of spores and what actions should be taken to reduce the contamination. These test kits can be used in rooms of your house, classroom, and/or office and can help you compare to the natural environmental background. The kits are very straight forward to follow including a booklet on how to use it, and some information regarding mould.

The Mould test kit plus also offers accredited laboratory identification of mould to the species levels and enumeration of detected mould species expressed as a number of colonies forming per plate. You will receive a full report and recommendations on how to improve your IAQ within 4 weeks of returning the samples to us.
Educational Videos
